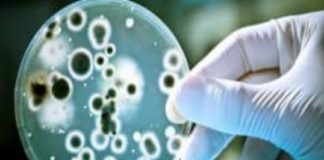

Tag: Chinese Nationals Arrested
അപകടകാരികളായ ഫംഗസ് യുഎസിലേക്ക് കടത്തി; രണ്ട് ചൈനീസ് പൗരൻമാർ പിടിയിൽ
വാഷിങ്ടൻ: അപകടകാരികളായ രോഗാണുക്കളെ യുഎസിലേക്ക് കടത്തിയ സംഭവത്തിൽ രണ്ടുപേർ പിടിയിൽ. ചൈനീസ് പൗരൻമാരായ യുൻക്വിങ് (33), സുഹൃത്തായ സുൻയോങ് ലിയു (34) എന്നിവർക്കെതിരെയാണ് യുഎസ് നീതിന്യായ വകുപ്പ് കേസെടുത്തത്. ഗൂഢാലോചന, തെറ്റായ വിവരങ്ങൾ...